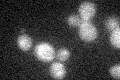
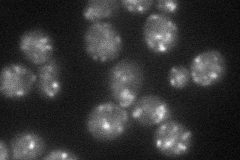
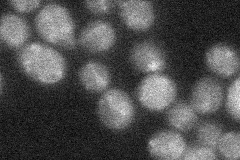

View description
Putative protein of unknown function, predicted to encode a triose phosphate transporter subfamily member based on phylogenetic analysis; similar to YOR307C/SLY41; deletion mutant has a respiratory growth defect
Localization:
Intensity:
Fold change:
Significance:
-
C’ GFP library in SD
below threshold16.2 -
N' NOP1pr-GFP in SD
punctate34.5551 -
N' TEF2pr-mCherry in SD

vacuole32.8406 -
N' NATIVEpr-GFP in SD
punctate23.6358 -
N' TEF2pr-VC and Cyto-VN in SD

below threshold26.7323 -
C’ GFP library in SD+DTT

cytosol14.070.86No -
C’ GFP library in SD+H2O2

cytosol15.90.98No -
C’ GFP library in Starvation Media

cytosol14.420.88No -
C’ GFP library on the background of Pup2-DaMP

below threshold -
C’ GFP library on the background of CCT mutant

below threshold15.6180.963746No
